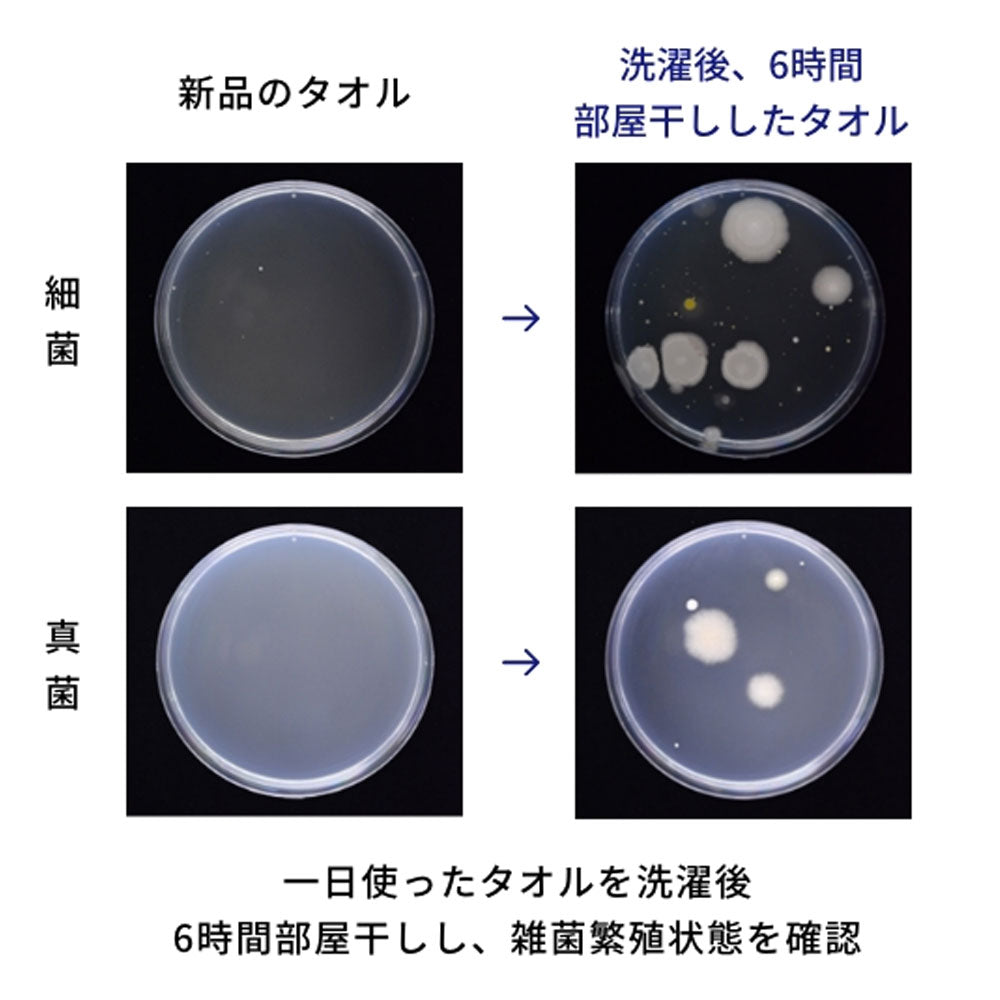
シルコット フェイシャルタオル 素肌おもい 40枚入 1 個

1
/
の
5
ユニ・チャーム株式会社
シルコット フェイシャルタオル 素肌おもい 40枚入 1 個
シルコット フェイシャルタオル 素肌おもい 40枚入 1 個
通常価格
¥434
通常価格
セール価格
¥434
単価
/
あたり
(税込み)
受取状況を読み込めませんでした
まさつを低減、シルクタッチシート。 タオルの雑菌、まさつが気になる方へ。
スキンケア新習慣!
●シルクタッチシートの繊維の細さは、一般的なタオルのパイルの細さに比べて20分の1(ユニ・チャーム調べ)!
ユニ・チャームが独自に開発したシルクタッチシートは、繊維が細くきめが細かいので、まさつを極力少なくすることができます。
天然コットンと植物由来のレーヨンを配合した安心・安全の日本製です。
●レーヨンの原料は木材由来のパルプ。バルブもレーヨンも森林認証材(適切に管理された木材)を使用しています。
●大判厚手タイプ(約200mm×200mm)で、1枚で顔全体の水分を、サッと吸収。
●すっぽり顔を覆えるサイズと、丈夫な質感
顔をすっぽり覆える大きさなので、洗顔後にサッと顔に当てるだけで顔全体の水分を吸い取ることができます。
シートにしっかりした厚みがあり、水分を吸収した後もボロボロになりません。
●お肌の水分を取り去りすぎない特殊な技術。
お肌の水分はサッとオフしたいけど、水分を取り去りすぎてしまうのは困る。そんな要望を、素材の選定や製造時の技術、厚みのバランスで叶えました。
●タオルは菌の温床になりやすい。
タオルは使いまわさず、一度使ったらすぐに洗うなどの注意を守らないと、菌の温床になってしまうことがあります。
シルコットフェイシャルタオルは使い切りシートだから、常に衛生的で、安心です。
●ティッシュのように、1枚ずつ取り出せるので便利!
●白基調のシンプルパッケージデザインでインテリアにもなじみます。 【素材】
レーヨン、コットン
【サイズ】
約200mm×200mm
【使い方】
・お風呂上がりや洗顔後、シートを広げて、お顔全体を包み込みます。
・お肌をこすらず、軽く押さえるようにして、水分オフして下さい。
・化粧水を浸せば、パックとしてもお使いいただけますが、十分水分を含ませてからお使いください。
・メイク落としやふきとりなどにもご使用頂けますが、十分水分を含ませ、シートが乾いた状態で肌をこすらないようにして下さい。 【使用上の注意】
・用途以外にはご使用にならないでください。
・本製品は使い捨てシートになります。
・お肌に合わない場合は、ご使用をお止めください。
・このシートはトイレに流さないでください。
・天然素材配合のため、ごくまれに色のついた点や繊維がみられる場合がありますが、品質には問題ありません。
★保管上の注意
・開封後は埃やゴミなどが入らないよう清潔に保管して下さい。
・小さなお子様の手の届くところ・直射日光や高温となる場所は避けて保管してください。
詳細を表示する